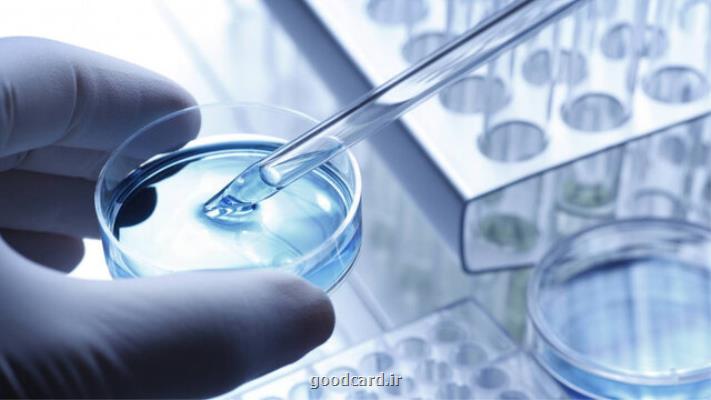
مأموریت های تحقیقاتی دانشگاه های علوم پزشکی

مأموریت های تحقیقاتی دانشگاه های علوم پزشکی
به گزارش کارت خوب، اولویت های تحقیقات و فناوری نظام سلامت کشور در چارچوب مأموریت های ملی جهت هزینه کرد سهم یک درصد آئین نامه اجرایی ماده ۵۶، به دانشگاه های علوم پزشکی به صورت رسمی واگذار شد.
به گزارش کارت خوب به نقل از ایسنا، در نشستی که با حضور ۱۷ رئیس و معاون تحقیقات و فناوری دانشگاه های علوم پزشکی و دکتر یونس پناهی معاون تحقیقات و فناوری وزارت بهداشت و مدیران معاونت برگزار شد؛ اولویت های تحقیقات و فناوری نظام سلامت کشور در چارچوب مأموریت های ملی جهت هزینه کرد سهم یک درصد آئین نامه اجرایی ماده ۵۶، به دانشگاه های علوم پزشکی به صورت رسمی واگذار شد.
دکتر یونس پناهی، با بیان این مطلب تصریح کرد: این مأموریت ها با هدف ارتقای تاثیرگذاری تحقیقات حوزه سلامت و پیرو اطلاع رسانی و پیگیری فرآیندهای منجر به تعریف پروژه های کلان منطبق با مأموریت های محوله به دانشگاه سپرده شده است.
منبع: كارت خوب
این مطلب را می پسندید؟
(1)
(0)
تازه ترین مطالب مرتبط
نظرات بینندگان در مورد این مطلب